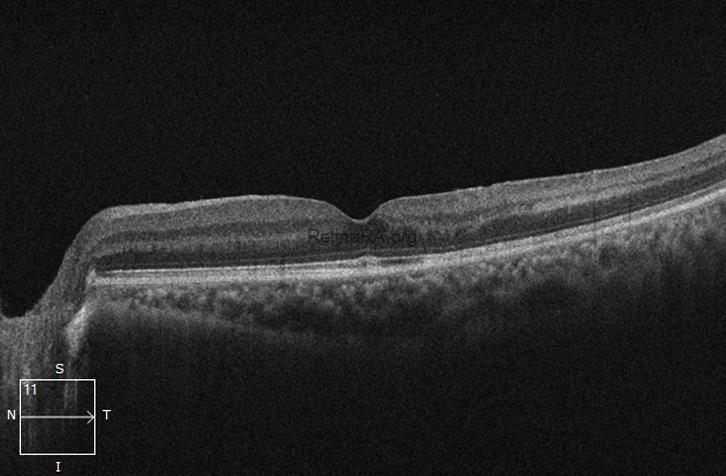
OCT-Scan-Post-op1mnrhRP

Subhyaloid Hemorrhage
A 45-year-old male patient presented with complaints of diminution of the vision in the left eye for 1 month. There was history of head trauma a month prior and there was diminution of vision following that. The best corrected visual acuity (BCVA) in the right and left eye was 20/20 and hand movements respectively. Patient presented with unremarkable anterior segment bilaterally. On dilated fundus evaluation, left eye examination revealed presence of large pre-retinal hemorrhage (appeared to have dehemoglobinised) which was estimated to be present in the sub-hyaloid space. Right eye fundus was clinically unremarkable. Patient was advised to undergo pars plana vitrectomy with internal limiting membrane peeling and fluid air exchange. On induction of posterior vitreous detachment, the dehemoglobinised blood started to clear up and was completely cleared up, other planned surgical steps were completed. Patient re-gained BCVA of 20/20 on 1 month follow up.
Fundus picture & OCT Scan (Presentation): At presentation depicts nearly arcade to arcade presence of sub hyaloid hemorrhage. OCT scan confirms the large pre-retinal hemorrhage with back shadow masking the underlying entire retinal architecture.


Fundus picture & OCT Scan (Post-intervention): Post-vitrectomy macula appears within normal limit. OCT depicts normal architecture of the retinal layers, with normal foveal thickness and maintained foveal contour.

Credit: Dr Deepanshu Agrawal, DO, DNB, FVRS
Consultant, Vitreoretina Services, Choithram Netralaya, Indore, India
Instagram account: @retin_o_vative

